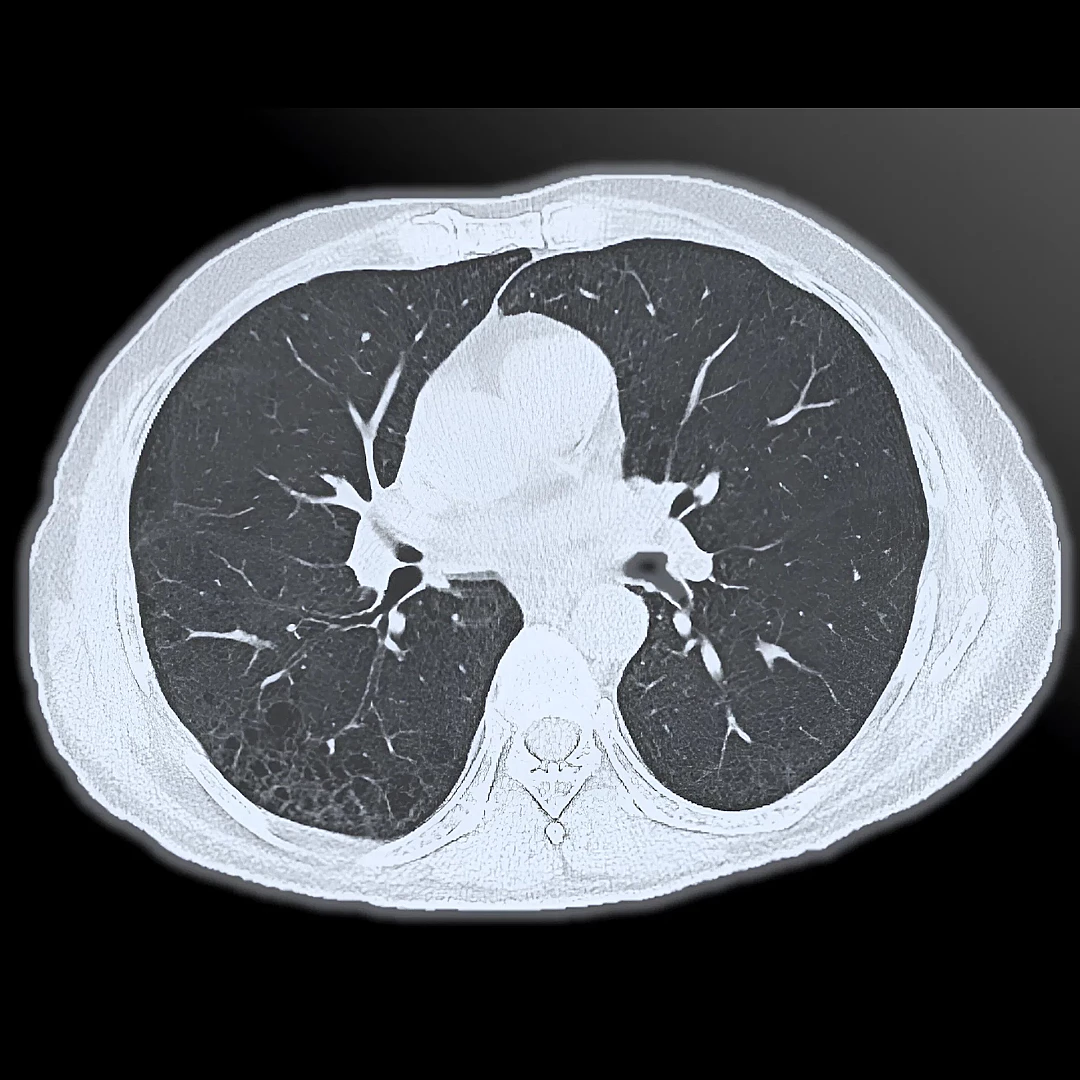
image/png

Brain CT
Brain CT provides rapid, detailed images of the brain to detect bleeding, strokes, tumors, or head injuries. It’s often used in emergency settings for quick and accurate neurological assessment.
Brain and Neck CT Angiography
Brain and Neck CT Angiography captures detailed images of blood vessels to identify blockages, aneurysms, or vascular malformations. It’s a fast, contrast-enhanced scan ideal for urgent evaluation of cerebrovascular conditions.
Standard & High-Resolution Chest CT
Standard and High-Resolution Chest CT provides detailed imaging of the lungs, airways, and chest structures to detect infections, tumors, or interstitial lung disease. High-resolution scans offer greater clarity for assessing subtle lung abnormalities with precision.
Pulmonary CT Angiography
Pulmonary CT Angiography visualizes the pulmonary arteries to detect blood clots, such as in pulmonary embolism. It’s a fast, contrast-enhanced scan offering accurate diagnosis of lung vascular conditions.
Low-Dose Lung Cancer Screening CT
Low-Dose Lung Cancer Screening CT is a quick, low-radiation scan designed to detect early-stage lung cancer in high-risk individuals. It enables early diagnosis, improving treatment outcomes and survival rates.
Virtual Bronchoscopy CT
Virtual Bronchoscopy CT creates a 3D view of the airways using CT data, simulating a real bronchoscopy without inserting a scope. It’s a non-invasive method to detect airway abnormalities, tumors, or obstructions.
Adult and Congenital Cardiac CT
Adult and Congenital Cardiac CT provides detailed images of the heart’s structure and vessels to assess congenital defects, coronary artery disease, or other cardiac conditions. It’s a non-invasive tool offering precise insights for diagnosis and surgical planning.
Coronary Angiography CT
Calcium Score and Coronary Angiography CT evaluate plaque buildup and blood flow in the coronary arteries to assess heart disease risk. It’s a non-invasive, fast scan that helps detect early signs of coronary artery disease.
Abdomen and Pelvic CT
Abdomen and Pelvic CT provides detailed cross-sectional images to diagnose conditions affecting the liver, kidneys, intestines, bladder, and reproductive organs. It’s a fast and accurate tool for evaluating pain, infections, or tumors in the abdominal and pelvic regions.
CT Enterography
CT Enterography is a specialized scan that captures detailed images of the small intestine to detect inflammation, tumors, or Crohn’s disease. It combines oral contrast and low-dose CT to provide clear, non-invasive evaluation of bowel conditions.
CT Urography
CT Urography provides detailed imaging of the kidneys, ureters, and bladder to detect stones, tumors, or urinary tract abnormalities. It’s a fast, contrast-enhanced scan ideal for comprehensive urinary system evaluation.
Virtual Colonoscopy CT
Virtual Colonoscopy CT uses advanced imaging to create a 3D view of the colon, detecting polyps or tumors without traditional colonoscopy. It’s a quick, non-invasive screening option for colorectal cancer.
Advanced Spinal CT
Advanced Spinal CT offers high-resolution imaging of the spine to assess fractures, disc problems, and spinal canal abnormalities. It’s a precise tool for diagnosing spine-related conditions, especially in trauma or surgical planning.
Advanced Bone and Joints CT
Advanced Bone and Joints CT provides detailed images of bones and joints to evaluate fractures, arthritis, and complex skeletal conditions. It’s ideal for orthopedic diagnosis, surgical planning, and sports injury assessment.
Aortic & Peripheral CT Angiography
Aortic and Peripheral CT Angiography visualizes blood vessels in the aorta and limbs to detect aneurysms, blockages, or vascular disease. It’s a fast, contrast-enhanced scan offering precise vascular assessment for diagnosis and treatment planning.